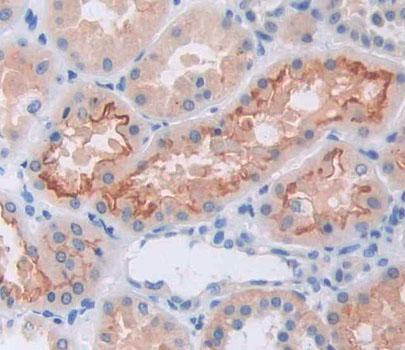

Polyclonal Antibody to Growth Differentiation Factor 11 (GDF11)


Product No.: PAC113Hu02
Organism species: Homo sapiens (Human)

Polyclonal Antibody to Centrosomal Protein 110kDa (CEP110)


Product No.: PAC373Hu01
Organism species: Homo sapiens (Human)

Polyclonal Antibody to Cholinergic Receptor, Nicotinic, Alpha 4 (CHRNa4)


Product No.: PAB913Hu01
Organism species: Homo sapiens (Human)

Polyclonal Antibody to Myelin Basic Protein (MBP)


Product No.: PAA539Hu06
Organism species: Homo sapiens (Human)

Polyclonal Antibody to Arylalkylamine-N-Acetyltransferase (AANAT)


Product No.: PAB937Ra01
Organism species: Rattus norvegicus (Rat)

Polyclonal Antibody to Cadherin, Myotubule (CDH15)


Product No.: PAC001Hu01
Organism species: Homo sapiens (Human)

Polyclonal Antibody to Cadherin, Myotubule (CDH15)


Product No.: PAC001Mu01
Organism species: Mus musculus (Mouse)
Polyclonal Antibody to Glutamate Receptor, Ionotropic, Kainate 2 (GRIK2)


Product No.: PAC018Hu01
Organism species: Homo sapiens (Human)

Polyclonal Antibody to Glial Cell Line Derived Neurotrophic Factor Receptor Alpha 2 (GFRa2)


Product No.: PAC168Hu01
Organism species: Homo sapiens (Human)

Polyclonal Antibody to Glial Cell Line Derived Neurotrophic Factor Receptor Alpha 2 (GFRa2)


Product No.: PAC168Mu01
Organism species: Mus musculus (Mouse)

Polyclonal Antibody to Collapsin Response Mediator Protein 1 (CRMP1)


Product No.: PAC404Hu01
Organism species: Homo sapiens (Human)

Polyclonal Antibody to Carnitine-O-Octanoyltransferase (CORT)


Product No.: PAC406Hu01
Organism species: Homo sapiens (Human)

Polyclonal Antibody to Carnitine-O-Octanoyltransferase (CORT)


Product No.: PAC406Mu01
Organism species: Mus musculus (Mouse)

Polyclonal Antibody to Mitofusin 1 (MFN1)


Product No.: PAC619Hu01
Organism species: Homo sapiens (Human)

Polyclonal Antibody to Mitofusin 1 (MFN1)

